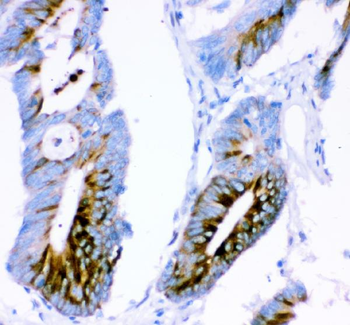

You have no items in your shopping cart.
Description
Research Area
Images & Validation
−| Tested Applications | ICC, IF, IHC, IP, WB |
|---|---|
| Dilution Range | WB (1:1000), ICC/IF (1:100) |
| Reactivity | Human, Mouse, Rat |
| Application Notes |
Key Properties
−| Host | Mouse |
|---|---|
| Clonality | Monoclonal |
| Isotype | IgG2b |
| Clone No. | N76/8 (Formerly sold as S76-8) |
| Immunogen | Synthetic peptide amino acids 164-197 (ATTPSQRSQLEAYSTLLANMGSLSQAPGHKVEPP) of mouse Ataxin-1. Rat: 100% identity (34/34 amino acids identical). Human: 88% identity (30/34 amino acids identical). |
| Target | Ataxin 1 |
| Molecular Weight | 85kDa |
| Purification | Protein G Purified |
| Conjugation | Unconjugated |
Storage & Handling
−| Storage | Maintain refrigerated at 2-8°C for up to 2 weeks. For long term storage store at -20°C in small aliquots to prevent freeze-thaw cycles. |
|---|---|
| Buffer/Preservatives | PBS pH 7.4, 50% glycerol, 0.1% sodium azide. Storage buffer changes when conjugated. |
| Concentration | 1 mg/ml |
| Expiration Date | 12 months from date of receipt. |
| Disclaimer | For research use only |
Alternative Names
−Similar Products
−Ataxin 1 Mouse Monoclonal Antibody [orb1152387]
FC, IHC, WB
Human, Mouse, Rat
Mouse
Monoclonal
Unconjugated
100 μgPhospho-Ataxin 1 (Ser775) Rabbit Polyclonal Antibody [orb155744]
IF, IHC-Fr, IHC-P, WB
Bovine, Canine, Equine, Gallus, Porcine, Rabbit, Sheep
Human, Mouse, Rat
Rabbit
Polyclonal
Unconjugated
50 μl, 100 μl, 200 μlAtaxin 1/ATXN1 Rabbit Polyclonal Antibody [orb259599]
FC, ICC, IF, IHC, WB
Human, Mouse, Rat
Rabbit
Polyclonal
Unconjugated
100 μgAtaxin-1 (phospho Ser776) rabbit pAb Antibody [orb769994]
ELISA, IF, IHC, WB
Human, Mouse
Polyclonal
Unconjugated
100 μl, 50 μl

Quality Guarantee
Explore bioreagents carefree to elevate your research. All our products are rigorously tested for performance. If a product does not perform as described on its datasheet, our scientific support team will provide expert troubleshooting, a prompt replacement, or a refund. For full details, please see our Terms & Conditions and Buying Guide. Contact us at [email protected].

Immunocytochemistry/Immunofluorescence analysis using Mouse Anti-Ataxin 1 Monoclonal Antibody, Clone N76/8. Tissue: Neuroblastoma cells (SH-SY5Y). Species: Human. Fixation: 4% PFA for 15 min. Primary Antibody: Mouse Anti-Ataxin 1 Monoclonal Antibody at 1:100 for overnight at 4°C with slow rocking. Secondary Antibody: AlexaFluor 488 at 1:1000 for 1 hour at RT. Counterstain: Phalloidin-iFluor 647 (red) F-Actin stain; Hoechst (blue) nuclear stain at 1:800, 1.6mM for 20 min at RT. (A) Hoechst (blue) nuclear stain. (B) Phalloidin-iFluor 647 (red) F-Actin stain. (C) Ataxin 1 Antibody (D) Composite.

Immunocytochemistry/Immunofluorescence analysis using Mouse Anti-Ataxin 1 Monoclonal Antibody, Clone N76/8. Tissue: Neuroblastoma cell line (SK-N-BE). Species: Human. Fixation: 4% Formaldehyde for 15 min at RT. Primary Antibody: Mouse Anti-Ataxin 1 Monoclonal Antibody at 1:100 for 60 min at RT. Secondary Antibody: Goat Anti-Mouse ATTO 488 at 1:200 for 60 min at RT. Counterstain: Phalloidin Texas Red F-Actin stain; DAPI (blue) nuclear stain at 1:1000, 1:5000 for 60 min at RT, 5 min at RT. Localization: Cytoplasm, Nucleus. Magnification: 60X. (A) DAPI (blue) nuclear stain. (B) Phalloidin Texas Red F-Actin stain. (C) Ataxin 1 Antibody. (D) Composite.
Quick Database Links
UniProt Details
−NCBI Gene Details
−NCBI Reference Sequences
−| Protein | NP_001186233.1 |
|---|
Documents Download
Request a Document
Protocol Information
Ataxin 1 Antibody (orb150766)
Participating in our Biorbyt product reviews program enables you to support fellow scientists by sharing your firsthand experience with our products.
Login to Submit a Review